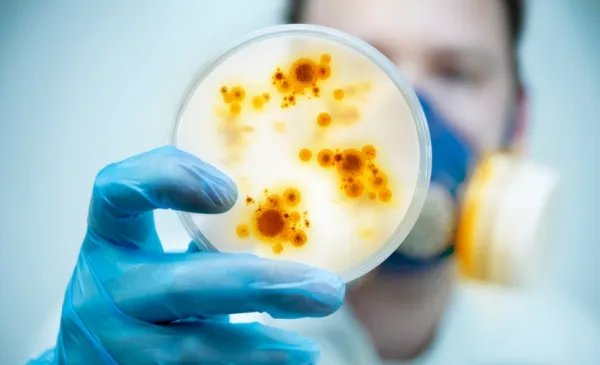
空气中到底有没有微生物呢?它们在哪里?

空气中到底有没有微生物呢?它们在哪里?空气中的微生物主要来自人类的生活和生产过程。环境空气中到处都是微生物,它们一直在我们身边。它们附着在灰尘或水滴上,并与载体一起悬浮在空气中。在高湿度、灰尘、通风不良和阳光不足的情况下,空气中的微生物不仅更丰富,而且存活时间更长。微生物造成的空气污染可使空气成为呼吸道传染病的传播媒介。因此,有必要检测空气中微生物的类型和数量。

如何检测空气中的环境微生物?为了检测空气中微生物的类型和数量,需要一个带特殊装置的采样器进行采样,然后通过培养基对采集的空气样本进行计数。影响微生物计数的因素很多,包括空气中微生物的捕获方法、捕获过程中微生物的杀灭效果以及培养温度和培养基的选择。目前,不可能找到一种能生长所有微生物的培养基,尤其是立克次体,而且病毒不能在无生命的培养基中生长,因此细菌和真菌通常被用作空气微生物检测的目标。

浮游生物采样器是一种适用于环境空气采样的采样器。它体积小、携带方便,是制药、洁净室、食品和饮料、医疗保健或任何需要无菌方法和工艺的研究/测试设施的理想选择。环境空气测试为基线确定、根本原因分析、趋势分析、生物体指示和高风险区域提供了极好的机会。如果检测到压缩空气中的微生物含量,可以结合使用德国德雷格压缩空气质量检测仪进行检测。
浮游细菌采样仪主要是一种通过多孔吸力进行空气采样,撞击仪器在一个培养皿中,空气中的微生物被“捕获”到AGAR培养基中,然后通过测试仪器,得出各种浮游细菌的环境指数,台式浮游细菌采样器,采样时其流量可达100 l/min,并且可以继续测试长达四个小时。浮游生物采样器是一个很好的工具,可以为风险确定设定基线,或提供空间数据来识别潜在风险区域。维护前后的样本也可以提供有价值的信息。
我觉得空气当中应该也是存在微生物的;他们一般都是会悬浮在空气当中,尤其是会在一些干燥的空气当中会比较多。
我觉得应该是有的,只不过我们现在没有发现,没有研究出来。
空气中有很多微生物存在;他们一般都是浮游在空气中,只不过因为体积太小,所以我们肉眼看不到。
空气中也是有微生物存在的;他们一般不能独立存在,都是依附在一定直径的颗粒物上面的。
